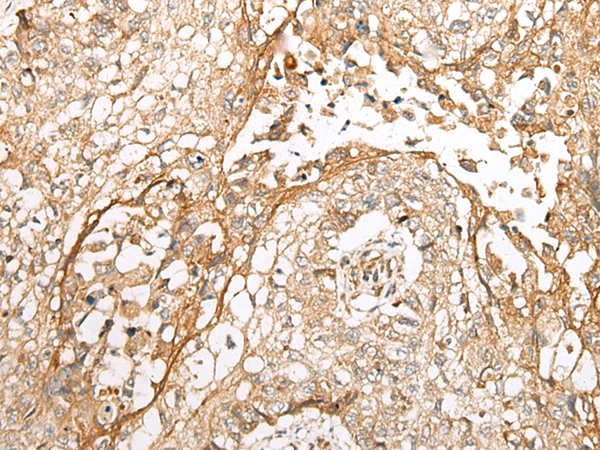

手機掃碼訪問本站

微信咨詢
|
Background: |
The globular WW domain, named for the conserved tryptophan residues in the protein motif present in various structural and regulatory proteins, is known to play a role in the mediation of protein-protein interactions. This gene encodes a ligand of the WW domain of the Yes kinase-associated protein. Readthrough transcription of the neighboring upstream gene, which encodes INO80 complex subunit B, into this gene generates a non-coding transcript. |
|
Applications: |
ELISA, WB, IHC |
|
Name of antibody: |
WBP1 |
|
Immunogen: |
Full length fusion protein |
|
Full name: |
WW domain binding protein 1 |
|
Synonyms: |
WBP-1 |
|
SwissProt: |
Q96G27 |
|
ELISA Recommended dilution: |
5000-10000 |
|
IHC positive control: |
Human liver cancer and human lung cancer |
|
IHC Recommend dilution: |
25-100 |
|
WB Predicted band size: |
29 kDa |
|
WB Positive control: |
Human fetal liver tissue and left kidney tissue lysates |
|
WB Recommended dilution: |
200-1000 |